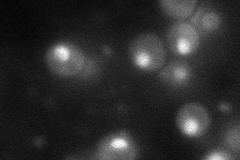
YGR156W
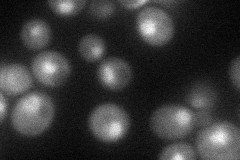
YGR156W

View description
Essential protein that is a component of CPF (cleavage and polyadenylation factor); involved in 3' end formation of snoRNA and mRNA; interacts directly with Pta1p; has similarity to mammalian Cleavage-Stimulation Factor CstF-64
Localization:
Intensity:
Fold change:
Significance:
-
C’ GFP library in SD

nucleus43.6 -
N' NOP1pr-GFP in SD
cytosol,nucleus69.0375 -
N' TEF2pr-mCherry in SD
nucleus47.8343 -
N' NATIVEpr-GFP in SD

nucleus37.662 -
N' TEF2pr-VC and Cyto-VN in SD

#N/A0 -
C’ GFP library in SD+DTT

nucleus42.480.97No -
C’ GFP library in SD+H2O2

nucleus38.090.87No -
C’ GFP library in Starvation Media

nucleus36.80.84No -
C’ GFP library on the background of Pup2-DaMP

nucleus -
C’ GFP library on the background of CCT mutant

nucleus46.61241.06895No
